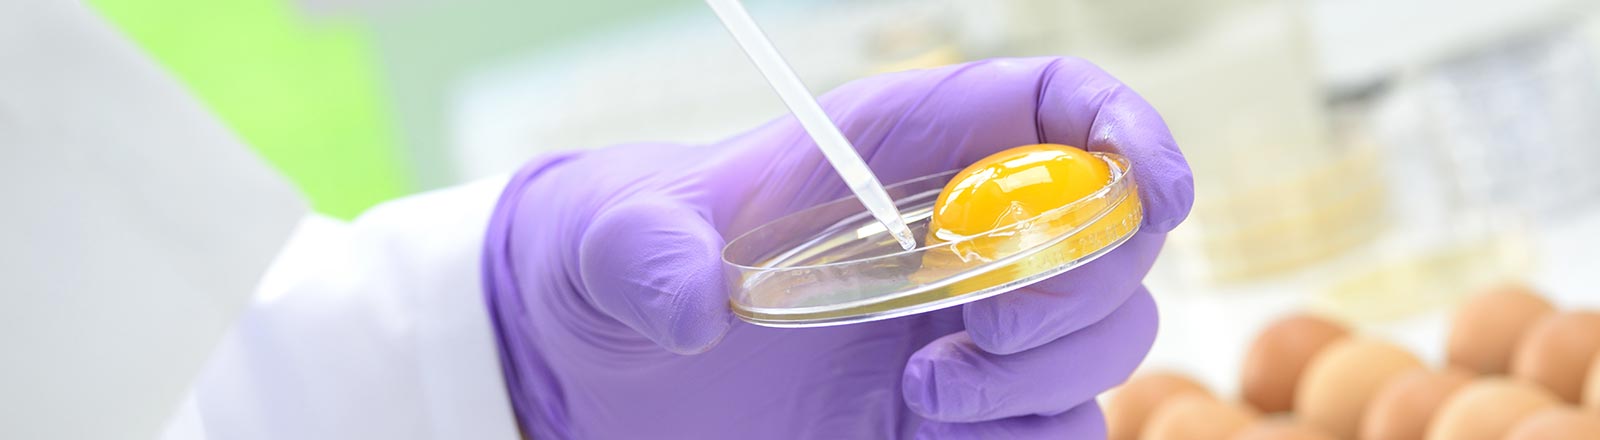
Qualitätsmanagement

Qualität wird bei uns groß geschrieben!

Noch nie war den Deutschen die Qualität ihrer Lebensmittel so wichtig wie heute. Daher achten auch wir von CHEFS CULINAR besonders darauf, woher unsere Produkte stammen und wie sie produziert werden. Definierte Verfahren, Qualitätssiegel und Prüfverfahren helfen uns bei der richtigen Auswahl. Denn wir legen Wert darauf, dass unsere Partner Qualität und Sicherheit genauso hoch schätzen wie wir.
Aber nicht nur unsere Partner nehmen wir kritisch unter die Lupe, auch wir betreiben in unseren Niederlassungen regelmäßig optimierte QM-Verfahren. Denn wir möchten, dass Sie Ihren Gästen mit ruhigem Gewissen nur beste Lebensmittel anbieten können.
ASC – Aquaculture Stewardship Council

Wir achten bei der Gestaltung unseres Sortiments stets auf Rückverfolgbarkeit und Nachhaltigkeit der Produkte, daher führen wir nun ASC-zertifizierten Fisch und Meeresfrüchte. Der Aquaculture Stewardship Council, kurz ASC, wurde im Jahr 2010 von WWF und IDH – also der „Sustainable Trade Initiative“ aus den Niederlanden – gegründet.
Verantwortung
Der ASC ist eine unabhängige, gemeinnützige Organisation von weltweiter Bedeutung. Das ASC-Siegel kennzeichnet Fisch und Meeresfrüchte aus verantwortungsvoller Zucht und honoriert dies. Verantwortlicher Umgang mit Mensch, Tier und Umwelt steht im Zentrum der Bemühungen.
Rückverfolgbarkeit
Jedes Unternehmen der Lieferkette muss eine eingehende Rückverfolgbarkeitsprüfung durchlaufen haben, um unter dem ASC-Logo vertrieben werden zu dürfen. So gewährleistet das Siegel, dass die Produkte in vollem Umfang den Anforderungen verantwortungsvoller Aquakultur entsprechen.
Globale Standards
Der ASC hat es sich zur zentralen Aufgabe gemacht die weltweiten Standards für verantwortungsvolle Aquakultur zu verwalten, die im WWF-„Aquaculture Dialogue“ ausgearbeitet wurden.
ASC-zertifizierte Produkte ermöglichen eine optimale Kaufentscheidung hinsichtlich Fisch und Meeresfrüchten aus Aquakultur.
MSC – Marine Stewardship Council

Bei der Gestaltung unseres Fisch-Sortiments achten wir auf die konsequente Durchsetzung eines verantwortungsbewussten Fischbestand-Managements. Wir legen hierbei besonderen Wert auf die enge Zusammenarbeit mit dem Marine Stewardship Council.
Verantwortungsbewusst Handeln
Der Marine Stewardship Council (MSC) ist eine unabhängige, globale und gemeinnützige Einrichtung, die es sich zur Aufgabe gemacht hat, eine Lösung für die Überfischung der Meere zu finden. Der MSC zertifiziert Fischerei-Unternehmen, die nachweislich umweltverträglich fischen sowie Lieferanten und den Fachhandel.
Die Grundsätze des Standards
Mit über 300 weltweit tätigen Experten aus Wissenschaft, Fischereiindustrie und Umweltorganisationen entwickelte Kriterien bilden die Grundlage für den MSC-Umweltstandard für nachhaltige Fischerei und basieren auf diesen Prinzipien:
- Schutz der Fischbestände
- Minimale Auswirkungen auf das Ökosystem
- Verantwortungsvolles und effektives Management
Das MSC-Logo kann auf Produkten verwendet werden, die aus MSC-zertifizierten Fischereien stammen. Jedes Mitglied der Lieferkette vom Kutter bis ins Restaurant muss diese unabhängige Prüfung nachweisen können. Alle CHEFS CULINAR Niederlassungen sind nach den Kriterien des MSC Chain of Custody Standard zertifiziert und dürfen MSC-zertifizierte Ware handeln. Neben Produkten aus konventioneller Fischerei finden Sie deshalb in unserem Fisch-Sortiment auch MSC-zertifizierte Artikel.
IFS Zertifizierung

CHEFS CULINAR hat sich bei der Zertifizierung der Lagerung und des Transports von Food- und Nonfood-Produkten für den IFS Logistics-Standard entschieden. Alle unsere Niederlassungen arbeiten nach den dafür notwendigen Verfahrensweisen und Vorschriften und werden regelmäßig auditiert.
Dieser Standard umfasst alle logistischen Aktivitäten für den Umgang mit bereits verpackten Produkten wie
- Transport
- Verpackung von primär verpackten Lebensmitteln
- Lagerung und/oder Vertrieb
Die Richtlinien gelten gleichermaßen für Lebensmittel und Non-Food-Produkte. Sie umfassen verpackte sowie unverpackte Lebensmittel, aber auch Produkte, die unter kontrollierten Bedingungen gelagert werden müssen – wie z. B. Fleisch, Brot, Milch, Öl usw.
Bio-Siegel

Das deutsche oder europäische Bio-Siegel bzw. EU-Bio-Logo erhalten nur Produkte pflanzlicher und tierischer Herkunft, die nach den festgelegten Anforderungen entsprechend der EG-ÖKO-VO produziert werden. Die EG-Verordnung Nr. 848/2018 und deren Durchführungsbestimmungen über ökologischen Landbau und die entsprechende Kennzeichnung sind die Grundlage für eine Zertifizierung.
Wo Bio draufsteht, ist auch Bio drin
Die Einhaltung der geltenden Bestimmungen wird in regelmäßigen Abständen von unabhängigen Stellen überprüft. Dabei werden alle einzelnen Stufen – von der Erzeugung bis zum Verkauf – zertifizieren.
HACCP Zertifizierung

Die Abkürzung HACCP steht für Hazard Analysis and Critical Control Points. Dies bezeichnet ins Deutsche übersetzt ein Eigenkontrollsystem. Hierdurch soll eine mögliche Gesundheitsgefährdung durch Lebensmittel weitestgehend ausgeschlossen werden. Dabei wird in einem HACCP-Konzept der gesamte Ablauf von der Warenannahme bis zur Speisenabgabe auf biologische, chemische und physikalische Gefahren analysiert. Durch die Einrichtung und laufende Überwachung von Lenkungspunkten (CCP) werden potenzielle Gefahren frühzeitig erkannt und abgestellt.
Das HACCP-Konzept fordert:
- alle in einem Unternehmen vorhandenen Gefahren einer Gesundheitsgefährdung, die von Lebensmitteln ausgehen kann, zu analysieren,
- alle für die Sicherheit der Lebensmittel kritischen Punkte zu ermitteln,
- Grenzwerte (z. B. Temperatur) für alle kritischen Punkte festzulegen,
- Verfahrensweisen zur laufenden Überwachung der kritischen Punkte einzuführen,
- Korrekturmaßnahmen für den Fall von Abweichungen festzulegen
- alle durchgeführten Maßnahmen zu dokumentieren und
- eine regelmäßige Erfolgskontrolle (Verifizierung) durchzuführen.
In Deutschland wurde das HACCP-Konzept erstmals in der Lebensmittelhygiene-Verordnung von 1998 verankert. Die EU-Verordnung 852/2004 schreibt seit 2006 die Anwendung des HACCP-Konzeptes in allen Unternehmen, die mit der Produktion, der Verarbeitung und dem Vertrieb von Lebensmitteln beschäftigt sind, verpflichtend vor.
GKT – Präqualifizierung für öffentliche Aufträge
Kompetenz, Qualität und Service
CHEFS CULINAR ist Ihr verlässlicher und kompetenter Partner. Als bundesweit größter Anbieter von Großküchentechnik stehen wir Ihnen professionell und serviceorientiert zur Seite.
 PQ-VOB Süd Reg.-Nr. 101.002357 / PQ-VOB Nord Reg.-Nr. 101.001634
PQ-VOB Süd Reg.-Nr. 101.002357 / PQ-VOB Nord Reg.-Nr. 101.001634
Vergabe- und Vertragsordnung für Bauleistungen
CHEFS CULINAR GROSSKÜCHENTECHNIK wurde in die Liste präqualifizierter Bauunternehmen beim Verein für die Präqualifizierung von Bauunternehmen für den Leistungsbereich 113-9, also für sonstige Gebäudeausrüstung, eingetragen.

Vergabe- und Vertragsordnung für Leistungen
CHEFS CULINAR GROSSKÜCHENTECHNIK ist von der Präqualifizierungsdatenbank von IHK und HWK für den Liefer- und Dienstleistungsbereich zertifiziert.
Wir sind als fachkundiges, leistungsfähiges und zuverlässiges Unternehmen für öffentliche Ausschreibungen, präqualifiziert. Sämtliche Nachweise für die Teilnahme an Vergaben werden uns damit bestätigt.
Qualitätsmarken

MEISTERFRISCH
Wir sind stolz auf unsere hauseigene Fleischqualitätsmarke MEISTERFRISCH, die wir in unseren CHEFS CULINAR Frischfleisch-Verarbeitungsbetrieben herstellen. Die einzelnen Rindfleischprodukte werden speziell für die Bedürfnisse unserer Kunden gewürzt, mariniert und grammgenau portioniert. Moderne, produktschonende Verpackungsmethoden sorgen für gleichbleibend hohe Qualität.
Mit Sicherheit gutes Fleisch: Neben den üblichen amtlichen und behördlichen Richtlinien stellt CHEFS CULINAR eigene weitergehende Standards auf, für deren Einhaltung unsere Partner garantieren. Und die wir regelmäßig überprüfen – für höchste Ansprüche.
STAR CULINAR
Unsere Eigenmarke STAR CULINAR steht für Artikel höchster Qualität für den besonderen Anspruch. STAR CULINAR ist eine Auswahl von Food-Produkten in Top-Markenqualität. Beste Rohwaren und sorgfältig veredelte Produkte werden exakt auf die Ansprüche einer hochwertigen, kreativen Küche zugeschnitten. Ein Premiumsortiment – kreiert für den anspruchsvollen Genuss.
Alle STAR CULINAR Artikel unterliegen besonderen Maßstäben hinsichtlich Qualität und Geschmack. Eigene Standards und präzise Vorgaben an die Hersteller helfen, diesem hohen Anspruch gerecht zu werden.
Qualitätssicherung

Im Mittelpunkt steht bei uns der hohe Anspruch an Service, Waren und Produkten. Um das zu gewährleisten, stützen wir uns bei CHEFS CULINAR auf ein über viele Jahre entwickeltes und optimiertes QM-Verfahren.
Zur regelmäßigen Überprüfung und Bewertung der Qualitätssicherungsmaßnahmen verwenden wir Verfahrensweisen wie Optimierungskreisläufe, interne und externe Audits und detaillierte Prozessbeschreibungen. Selbstverständlich sorgfältig dokumentiert und in festgelegten Zeitabständen aktualisiert. Wir führen laufend Qualitäts- und Hygienekontrollen in unseren Produktions- und Lagerstätten durch und der Maschinenpark wird laufend auf dem neuesten Stand der Technik gehalten.
Zudem legen wir besonderen Wert auf Personalschulungen: Regelmäßige Schulungs- und Fortbildungveranstaltungen sowie eine Sensibilisierung für QM-Fragen sorgen dafür, dass bei CHEFS CULINAR alle mithelfen, den eigenen Qualitätsansprüchen zu genügen.
Zertifikate für das Unternehmen CHEFS CULINAR
Bei CHEFS CULINAR verstehen wir Qualität ganzheitlich. Sie zeigt sich nicht nur in der Frische und Zuverlässigkeit unserer Produkte, sondern auch in der Art und Weise, wie wir als Unternehmen handeln. Wir arbeiten fortlaufend daran, ökologische, soziale und ökonomische Werte miteinander zu verbinden. Denn für uns ist Qualität mehr als ein Versprechen: Sie ist die Grundlage für eine nachhaltige Zukunft.
Energiemanagement

Wir engagieren uns im Sinne der Nachhaltigkeit für eine fortlaufende Verbesserung der Energieeffizienz. Mit der erfolgreichen Zertifizierung unseres Energiemanagementsystems nach ISO 50001 haben wir ein starkes Fundament dafür geschaffen. Nun arbeiten wir daran, unser Energiemanagement stetig zu erweitern und qualitativ zu verbessern.